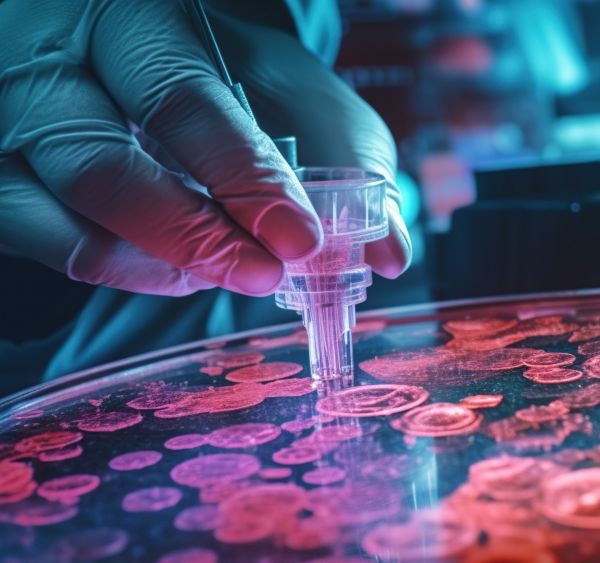

BioarabaIkerketa

2020tik, Vital Fundazioak 19 ikerketa-proiektu bultzatu ditu gure lurraldean, besteak beste, BioAraba Arabako Bioteknologia Institutuaren eskutik.
Informazioa
Osasun-ikerketari dagokionez, hainbat eremu hartuko dituzte barnean. Bioaraba Osasun Ikerketa Institutuaren bidez, honako hauek jarriko dira abian:
1.- Aldebakarreko hipofuntzio vestibular kronikoa duten pertsonentzat programa laguntzaile gisa gainbegiratutako ariketa fisikoa: Estudio Exervest
Pertsona batzuek orekan alterazioak izaten dituzte modu kronikoan, eta horrek jarduera fisikoa murriztera, bizimodu sedentarioa izatera eta, beraz, beste osasun-arazo batzuk izatera eramaten ditu. Azterketa honen bidez, bertigoa duten pertsonentzako ariketa fisikoko programa gainbegiratu bat ebaluatzea proposatzen da, saiakuntza kliniko baten bidez, orekaren hobekuntza, bizi-kalitatea eta ongizate mentala aztertzeko.
Azterlanaren buru Asier Lekue da, otorrinolaringologiako ikertzaile eta espezialista, eta Bioaraba Osasun Ikerketa Institutuko Jarduera Fisikoa, Ariketa Fisikoa eta Osasuna ikerketa-taldearekin batera parte hartzen du.
2.- Ahoko sakarosa emateko eraginkortasunaren alderaketa, % 24koa, bi minutu lehenago, jaioberrian prozedura mingarria egiten den unean bertan egin beharrean.
Gaur egun, Arabako Unibertsitate Ospitaleko Neonatologia Unitatean, haur jaioberriei azukre (sakarosa) bat ematen zaie ahotik, maniobra mingarri bat egin baino bi minutu lehenago, hala nola odola ateratzea edo bide bat hartzea, mina gutxitzeko asmoz. Azterlan honen helburua da ohiko praktika hori produktu bera ematea mingarria izan daitekeen maniobraren aurretik. Konparazio horren emaitzak, jaioberriaren mina baloratzen duten test batzuen bidez neurtuta, gomendioak egiteko balioko du, haurtxoetan mina gutxitzeko azukrea emateko unerik egokienari begira.
Azterketa Neonatologia Unitateko erizain talde batek planteatu du, Bioaraba Osasun Ikerketa Institutuko Zainketen Ikerketa taldeko Oihana Lópezek gidatuta.
3.- Psikobioma aztertzen: mikrobioma ikertzen antsietatean eta depresioan
Azterlanaren bidez, antsietatea eta depresioa duten pazienteen hesteetako eta ahoko floran dauden mikroorganismoen profilak sintoma horiek ez dituztenen profilak ez diren beste batzuk diren ebaluatu nahi da. Horrela, mikroorganismoren baten edo batzuen presentziak sintoma edo nahaste mental horien biomarkatzaile gisa jardun dezakeen eta tratamenduaren diagnostikoan eta bilakaeran lagundu dezakeen ikusi nahi da.
Andrea García da proiektuaren burua, psikiatrian aditua eta Bioaraba Osasun Ikerketa Institutuko Gaixotasun Mental Larriaren ikerketa-taldekoa, eta estatu mailako ikerketa multizentrikoan kokatzen da.
4.- Alkohola erabiltzearekin gazteen itxaropenetan aldaketak sustatzeko tresna baten eraginkortasuna
Ikerketa proiektu baten lehen fasea da. Bertan, nerabeekin lan egingo da alkoholaren kontsumoari buruzko pertzepzioa ezagutzeko, eta alkoholaren kontsumoari eta haren ondorioei buruzko errealitatea hurbilduko duen tresna teknologiko bat elkarrekin diseinatuko da. Nerabeek aktiboki parte hartuko dute tresna hori diseinatzen azterlanaren fasean, pertzepzio okerrak aldatzeko eta alkoholaren kontsumoarekin lotutako jokabideak aldatzeko.
Iratxe Salcedo da azterlanaren burua, Arabako Errioxako ESIko pediatra eta Bioarabako Ama-haurren Ugalketa eta Osasun arloko koordinatzailea.
5.- Alterazio kognitiboak elikadura-jokabidearen nahasmenduetan eta horiek hesi hematoentzefalikoarekin eta hanturarekin duten lotura
Proiektuak anorexia nerbiosoari buruz gehiago jakin nahi du, azken bi urteetan gaixotasun horren intzidentzia handitzen ari baita COVID-19aren pandemiaren ondorioz. Ikertzaile-talde honek egiaztatu nahi du elikadura-nahasmenduak dituzten pertsonen funtzio kognitiboetako alterazio batzuk hesi hematoentzefalikoko arazoekin lotuta dauden, hau da, garuna eta haren osagaiak eta odol-zirkulazioa bereizten dituzten mintzetan.
Ikerketaren buru Noelia Olmo da, psikiatrian aditua, eta Bioaraba Osasun Ikerketa Institutuko psikiatriako ikerketa-taldeetako bik laguntzen dute.
6.- Gripearen txertoak COVID-19az kutsatutako pazienteengan duen eraginaren ebaluazioa.
7.- Biriketako simulagailuaren bidez COVID-19aren aurka borrokatzeko arnasketa-terapiak garatzea eta baliozkotzea.
8.- Paziente kritikoen SARS-CoV-2 birusak eragindako infekzio bakteriano eta fungikoek eragindako gaininfekzio multierresistenteak. Analisi farmakozinetiko-farmakodinamikoa, tratamendu antibiotikoa optimizatzeko.
9.- Inguruen simulazioan oinarritutako ikaskuntza-plataforma.
10.- COVID-19 pazienteak artatzeko esperientzia. Fakultatiboen bizipena: zailtasunak, indarguneak eta gatazka etikoak.
11.- Konplikazio kardiobaskularrak COVID-19aren infekzioa eta kalte miokardikoa duten pazienteetan.
12.- Zainketa intentsiboen osteko sindromea COVID-19a duten pazienteetan. Intzidentzia eta lotutako faktoreak.
13.- Zer eginkizun dute D bitamina, zink eta selenio kontzentrazio serikoek COVID-19ko pazienteengan?
14.- Eragina osasun mentalean eta osasun-arretako beharretan, COVID-19aren ondorioz.
2022ko MEMORIA ZIENTIFIKOA HEMEN KONTSULTATU